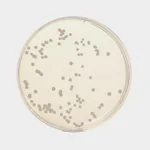

Himedia Anti Q Antiquencher mounting reagent
✨AI 추천 연관 상품
AI가 분석한 이 상품과 연관된 추천 상품들을 확인해보세요
연관 상품을 찾고 있습니다...
null
Product Name | Anti Q™ Antiquencher mounting reagent |
SKU | TCL193 |
Customized Product Available | No |
🏷️Himedia 상품 둘러보기
동일 브랜드의 다른 상품들을 확인해보세요

Himedia
Himedia Dulbecco`s Modified Eagle Medium (DMEM), High glucose w/ 4.5gms Glucose per litre w/o L-Glutamine, Calcium chloride, HEPES buffer, Sodium pyruvate and Sodium bicarbonate
432,000원

Himedia
Himedia Triton X-100 Solution, 20% Sterile filtered
506,000원

Himedia
Himedia Anti Q Antiquencher mounting reagent
614,000원

Himedia
Himedia HEPES Solution 1M in normal saline
336,000원
Himedia
Himedia Sabouraud Dextrose Agar, Granulated
48,000원
배송/결제/교환/반품 안내
배송 정보
기본 배송비 |
| 교환/반품 배송비 |
|
---|---|---|---|
착불 배송비 |
| ||
교환/반품 배송비 |
|
결제 및 환불 안내
결제수단 |
|
---|---|
취소 |
|
반품 |
|
환급 |
|
교환 및 반품 접수
교환 및 반품 접수 기한 |
|
---|---|
교환 및 반품 접수가 가능한 경우 |
|
교환 및 반품 접수가 불가능한 경우 |
|
교환 및 반품 신청
교환 절차 |
|
---|---|
반품 절차 |
|
문의 0
로그인 후 문의를 할 수 있습니다.